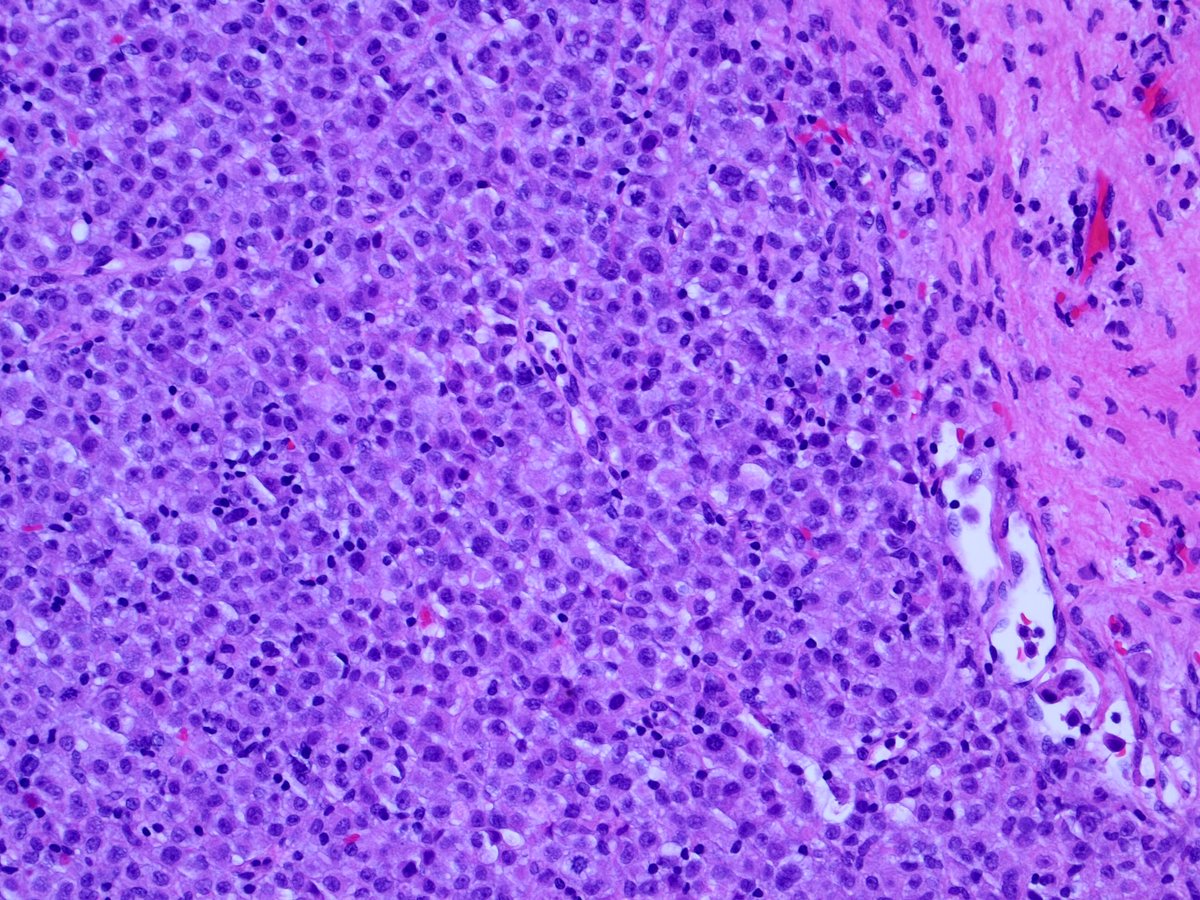
3. Corresponding permanents:

#Breastpath #cytopath
52 Year old female; multifocal right sided breast cancer undergoing mastectomy with SLN bx.
Intraoperative sentinel node touch prep shown. If cancer —> axillary dissection.
3 pages of pics, and a poll.
1/4
52 Year old female; multifocal right sided breast cancer undergoing mastectomy with SLN bx.
Intraoperative sentinel node touch prep shown. If cancer —> axillary dissection.
3 pages of pics, and a poll.
1/4
2/4
Tagging some breast/cyto folks:
@Jbird42077503 @RoncinMD @KaravelicMD @ADamronMD @GuzmanArocho @MComptonMD @Sara_Jiang @MauroSaieg @ZMaleki_cyto @mdlozanoe @ac_pathgal @VandaTorousMD @sza_jhcyto @VarshaManuchaMD @LizaMQuintana @ADamronMD @oreoimc @doc_kartik @cjvand
Tagging some breast/cyto folks:
@Jbird42077503 @RoncinMD @KaravelicMD @ADamronMD @GuzmanArocho @MComptonMD @Sara_Jiang @MauroSaieg @ZMaleki_cyto @mdlozanoe @ac_pathgal @VandaTorousMD @sza_jhcyto @VarshaManuchaMD @LizaMQuintana @ADamronMD @oreoimc @doc_kartik @cjvand
4/4
Diagnosis? Comments encouraged. Histology correlation and discussion to follow.
Diagnosis? Comments encouraged. Histology correlation and discussion to follow.
1. Discussion: Interesting voting trend. “Benign” held the early slight majority, then some astute people suggested metastatic lobular carcinoma. The voting them swung decidedly towards “cancer”!
6. Some annotated images showing the atypical features of the red box cells above.
None of these are specific; histiocytes may resemble lobular cancer cells. However, taken together, these atypical features should raise concern for malignancy, and prompt a frozen section.
None of these are specific; histiocytes may resemble lobular cancer cells. However, taken together, these atypical features should raise concern for malignancy, and prompt a frozen section.
8. Also welcome any input form #cytopath experts, I am definitely not one ( @doc_kartik @Sara_Jiang @DCSkipperDO @oreoimc @DrGeeONE @VandaTorousMD and anyone else)
9. Our approach is similar to that outlined by @MComptonMD et al:
https://pubmed.ncbi.nlm.nih.gov/29566947/
If you are less than 100% sure of 1) diagnosis of metastatic ca, and 2) size of focus, defer. Axillary dissection has significant morbidity, and can’t be undone!
Thanks all!
https://pubmed.ncbi.nlm.nih.gov/29566947/
If you are less than 100% sure of 1) diagnosis of metastatic ca, and 2) size of focus, defer. Axillary dissection has significant morbidity, and can’t be undone!
Thanks all!

 Read on Twitter
Read on Twitter